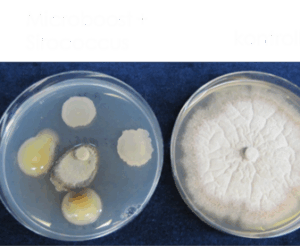

Om prosjektet
Norske skogplanteskoler produserer mer enn 40 millioner planter, hovedsakelig gran, for å sikre foryngelse på
skogarealer, som settes ut i naturen hvert år, og i 2020 brukte norske skogeiere 235 millioner kroner til innkjøp og
planting av nye skogplanter.
Småplanter produseres fra frø i veksthus og utendørs på planteskolene før de som 1-2
år gamle plantes ut på hogstflater. Småplantene er sårbare for soppangrep som kan gi store skader på skudd, grener
og røtter og i verste fall føre til at plantene dør. I norske skogplanteskoler kan det være opp til 25 % svinn fra såing til
salgsklare planter, som følge av soppsykdommer forårsaket av arter i slekter som Botrytis, Sirococcus, Gremmeniella
og Rhizoctonia. Enkelte år kan svinnet være så høyt som 60 %.
Det finnes i dag få godkjente soppmidler (fungicider) for bruk i skogplanteskoler og ingen godkjente soppmidler for bruk på skogsfrø. I tillegg har fungicidresistens blitt et økende problem. Agribiotix AS ønsker å tilby en innovativ og bærekraftig biokontroll-løsning for å bekjempe soppsykdommer på granplanter i skogplanteskolene.
Dette vil redusere svinn og økonomiske tap og minimere negative effekter på miljøet. I dette kvalifiseringsprosjektet vil vi finne ut om stedegne bakterier fra norsk landbrukog jordbruk har egenskaper som gjør dem egnet til biokontroll av soppsykdommer i norske skogplanteskoler.
Vi har tidligere isolert bakterier med lovende egenskaper både fra jord og planter.
Dersom de stedegne bakteriene har de ønskede egenskapene in vitro og i små veksthusforsøk in vivo vil vi søke om midler til å utvikle innovasjonen videre i et hovedprosjekt. Der vil vi utvikle prototyper av formuleringer og sammenligne deres effekt på sykdom og plantevekst med eksisterende kjemiske løsninger innendørs og utendørs i planteskolene og utendørs i plantefelt.